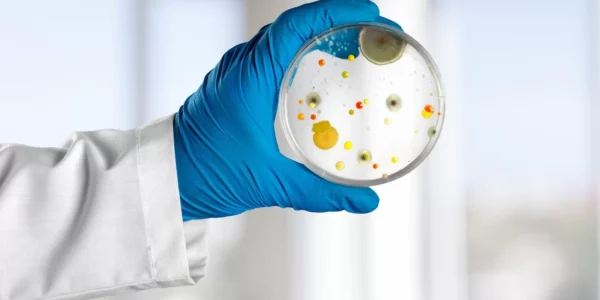
A person wearing a white lab coat and blue glove holds a petri dish with various colorful bacterial colonies growing on its surface, against a blurred indoor background.

Your Privacy Matters
Mold Assist values your privacy. The information you provide will be kept confidential and will never be shared with third parties.
Request an Emergency Consultation
Need urgent help with Mold damage? Fill out the form with your name, contact details, and a brief description of your situation. Our team will get back to you promptly—24/7 emergency response available across the GTA.

